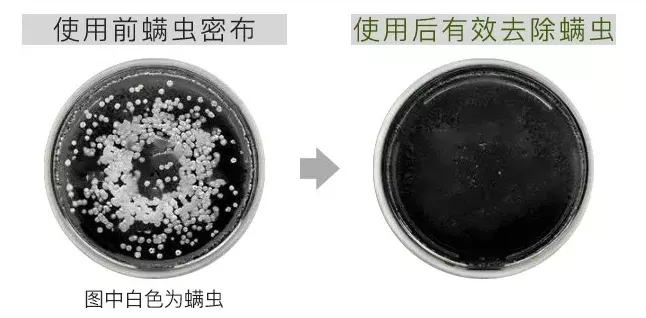

南京同仁堂创建于清康熙八年,自雍正元年起正式供奉皇室,到现在已经300多年历史,是家喻户晓的老品牌了。这款何首乌洗发水由同仁堂专研,每一瓶都严格把控品质,通过国家层层质检,证书、资质一应俱全。畅销15个国家10多年,靠的就是实打实的口碑和效果!为我们国货狠狠长脸~何首乌洗发水,目前已帮20万买家告别白发烦恼,体验好、见效快,赢得了无数粉丝的青睐!广州的何小姐35岁了,生完二胎后体内激素变化大,加上过度操劳,大把大把掉头发,白头发也多了很多,看着憔悴又显老。用了何首乌洗发水不到15天,基本不脱发了。2个月的时候,前额长出了许多小绒毛,白发几乎没有了,同事还以为她去植发了!杭州的沈先生是遗传的少白头,30岁看着像40岁,只能不停地染发掩盖。用了何首乌洗发水以后,黑发长出来了,头发乌亮亮的,中年大叔逆袭成帅气小鲜肉,整个人都自信了!苏州宝妈陈小姐头发白得很快,经常去店里染黑,发质严重受损,看着像一头枯草一样。何首乌洗发水连用一个月,头发变黑变亮了,公司同事都让她帮忙带2瓶!上海80后陈小姐每天必洗头,不然第二天头发就会粘在一起,还起屑发痒,打理头发特费时。用了何首乌洗发水半个月,3天不洗头头皮还能保持清爽干净,省了她不少时间! 不管你什么类型的白发,主要原因都是发丝缺少营养和微量元素,无法合成黑素而褪成白发。南京同仁堂何首乌洗发水,选用广西瑶族土生土长的稻穗发酵原液。
添加何首乌、当归、黑灵芝、苦参、生姜等养发植萃的精华。促进促进黑色素又多又快合成的同时,直击脱发根源,让发量蹭蹭暴涨!在民间,更有着“乌发神草”之称,就算你长了满头的白发也能救回来!同仁堂选用的正是长白山3年生的黑灵芝,以人工进行采摘加工,富含钙、锌、铁、铜、锗等诸多营养成分。这些成分在头发缺少生长营养和微量元素的时候就是它们的救星!能够帮助头发生成黑色色素,让它变得乌黑粗壮。跟何首乌、当归一起,堪称黑发界的三大“顶流”,深入头皮修复毛囊细胞,长出来的头发漆黑如墨、坚韧粗壮。还添加生姜、苦参两种珍贵草本,焕活萎缩、退化毛囊,激发毛囊育发、固发能力。生姜富含氨基酸和多肽、蛋白质、生物碱,这都是促进毛发生长的营养物质,进一步促进毛发生长;不仅促进头发生长,还可以使头发直径增厚,对头发细软有针对性的改善效果;
呵护受损发质,提升头发韧性,减少掉发、断发,头发越养越浓密;苦参被称为“天然生发液”,能从根本上焕活和修复枯死毛囊,促进毛囊对何首乌等营养物质的吸收。洗一洗,让头皮真正健康起来,白发变黑的同时强根止脱、孕育新发。一瓶一个周期,头发变白实实在在看得见,发量真的暴增,看起来年轻10岁不止~ 长期染发、用错洗发水,让本已破败不堪的毛囊“雪上加霜”,造成早衰白发、干枯、分叉!何首乌洗发水,“先洗,后养”,稻米精华含丰富蛋白质成分,强韧发根、滋养毛囊,洗1次,毛躁的头发变得水润顺滑!还特别添加护发成分,每次洗完,头发摸起来都很柔软顺滑,头发一梳到底,堪比专业级发廊护理效果!何首乌、当归含有丰富的高分子多糖以及微量元素,抚平头发干枯毛躁,令头发水水润润,比德芙还要纵享丝滑~~
用它洗几次,频繁烫染而干枯的发丝,变得像瀑布一样柔顺,随便一甩头,就是电视剧女一号! 去屑止痒
熬夜、饮食油腻、作息不规律,都会导致皮脂腺代谢紊乱,头螨大爆发。针对头螨问题,洗发水中还专门加入柠檬酸来克制和消灭头螨。早在公元前两千五百年前,人们就已发现柠檬的护发功效,它在古代就是达官贵人清洁头发的”洗发液”。它具有较高的酸性,能深入毛囊清洁,吸附包裹堵塞毛囊的脏东西。毛囊干净了,脂肪油脂就少了,干净的头皮环境下头螨无法繁殖,自动消失。哪怕是再油腻的“油头精”们,用它洗上几次,清洁的同时调节油脂,改善头皮屑、骚痒等问题。不仅如此,对于螨虫造成的痘痘、发炎,也有很好的镇定修复作用。用它洗一洗,没几天就褪去了,头皮不痛不痒,心情都好了很多!
江西的刘小姐最近头上奇痒无比,头屑一抓一大把。去医院一检查发现是头螨超标!用何首乌洗发水一个月,头皮不痒了,刺眼的头皮屑也变少了,整个人都有了自信!当大家还在争论到底是国产洗发水好用,还是国外牌子更香时,中草药精华,营养沁入头皮的同时,洗完以后发丝根根清爽、蓬松,带着淡淡草本清新0硅油,0甲醛,0尼泊金酯,0硫酸盐,0二噁烷等有害化工成分。
原价128元1瓶,今日有书限时活动,买多少送多少!
无论是对头皮的滋养还是毛囊的修复,都有一个持续性的过程,建议大家趁优惠多囤几瓶!
 *图片来源网络,如有侵权请联系删除
*图片来源网络,如有侵权请联系删除 *图片来源网络,如有侵权请联系删除
*图片来源网络,如有侵权请联系删除 *图片来源网络,如有侵权请联系删除
*图片来源网络,如有侵权请联系删除